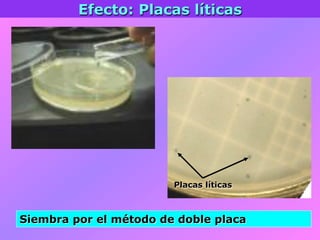
Efecto: Placas líticas
Placas líticas
Siembra por el método de doble placa

El documento describe la historia del descubrimiento de los virus y bacteriófagos desde principios del siglo XX, así como los avances en las técnicas de cultivo, observación e investigación que han permitido comprender mejor su estructura, replicación y diversidad. Los virus son agentes infecciosos que dependen de las células huésped para replicarse y presentan una gran variabilidad en tamaño, material genético, huéspedes y estrategias de infección.